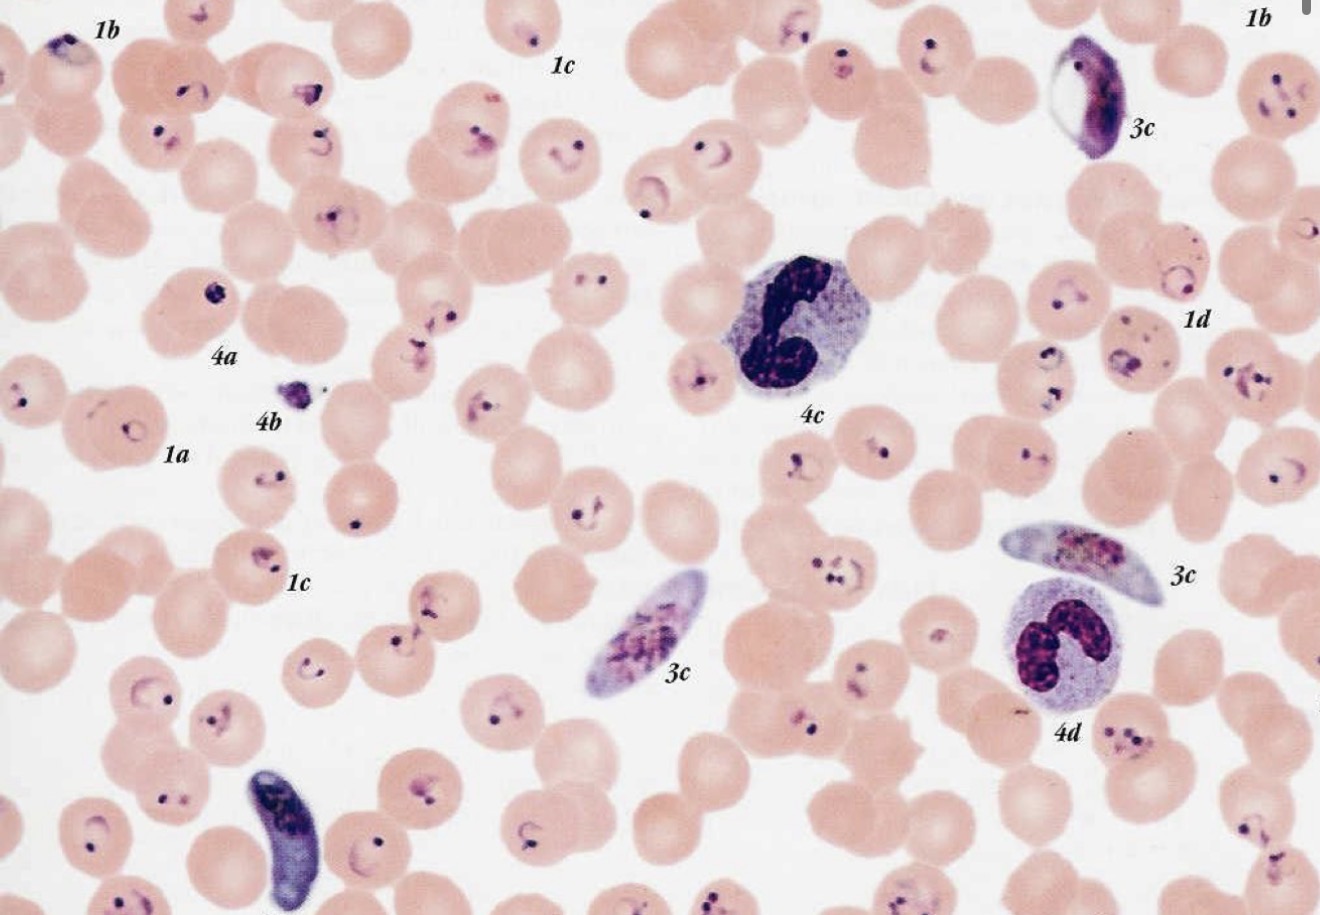
knowt flashcard image
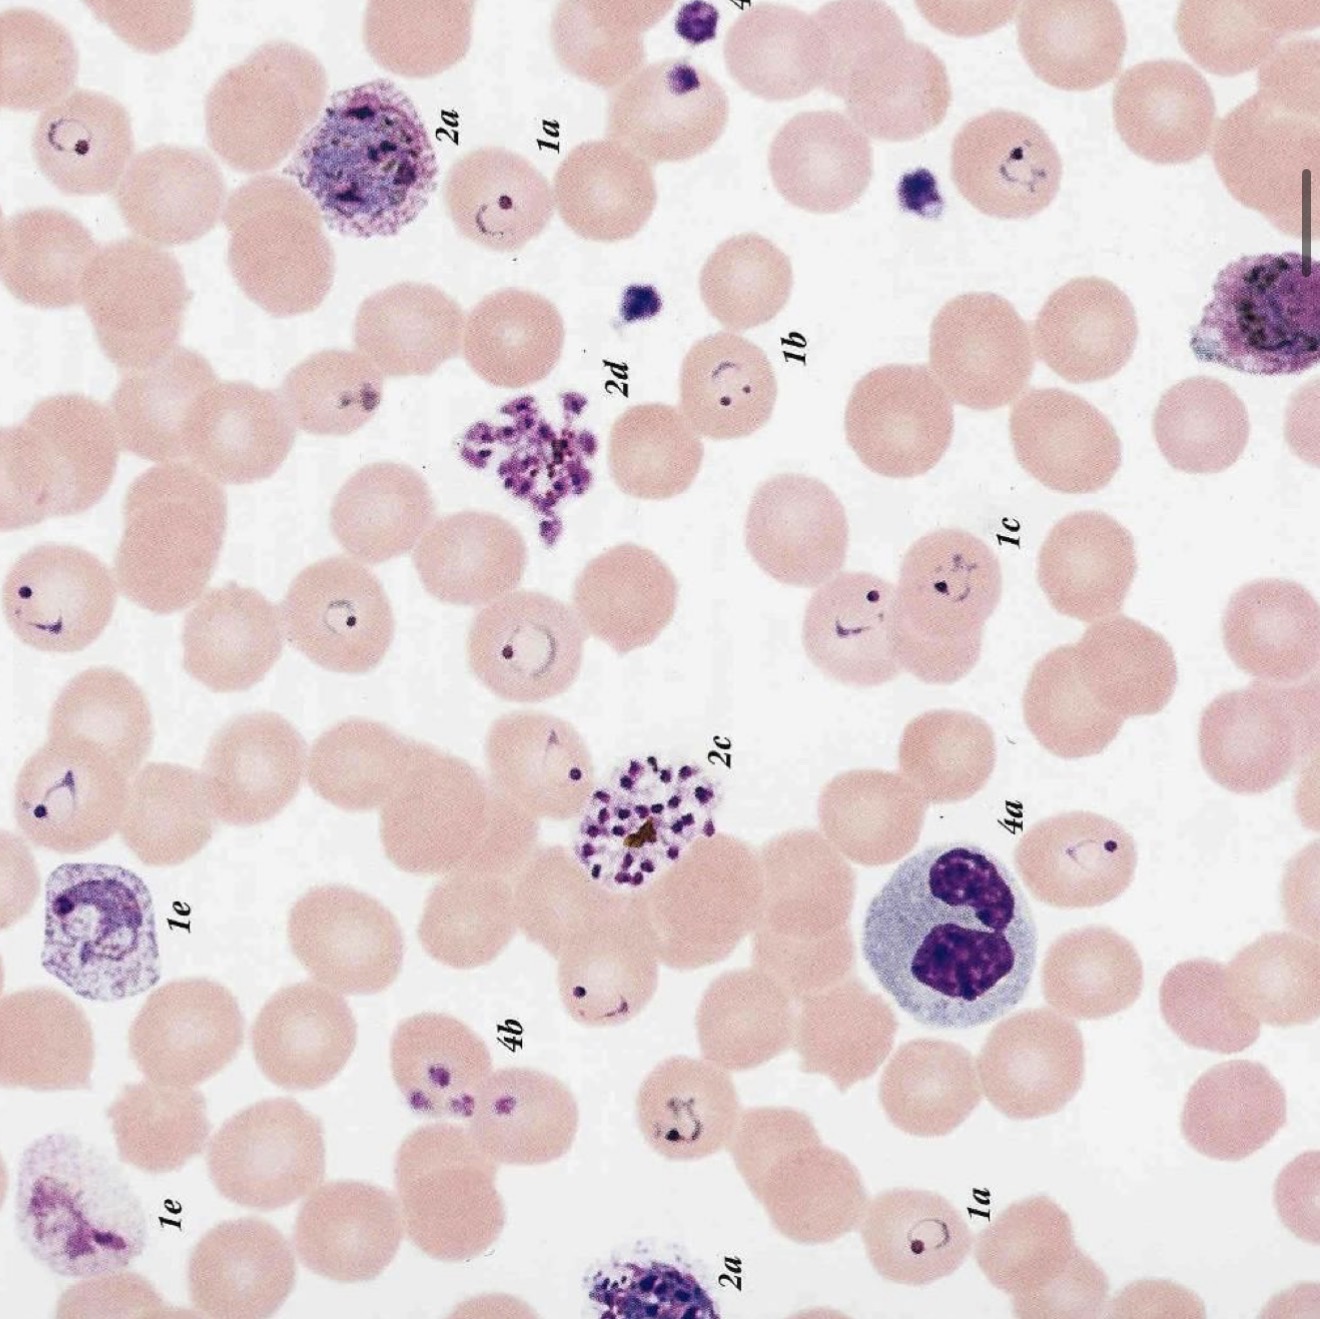
knowt flashcard image
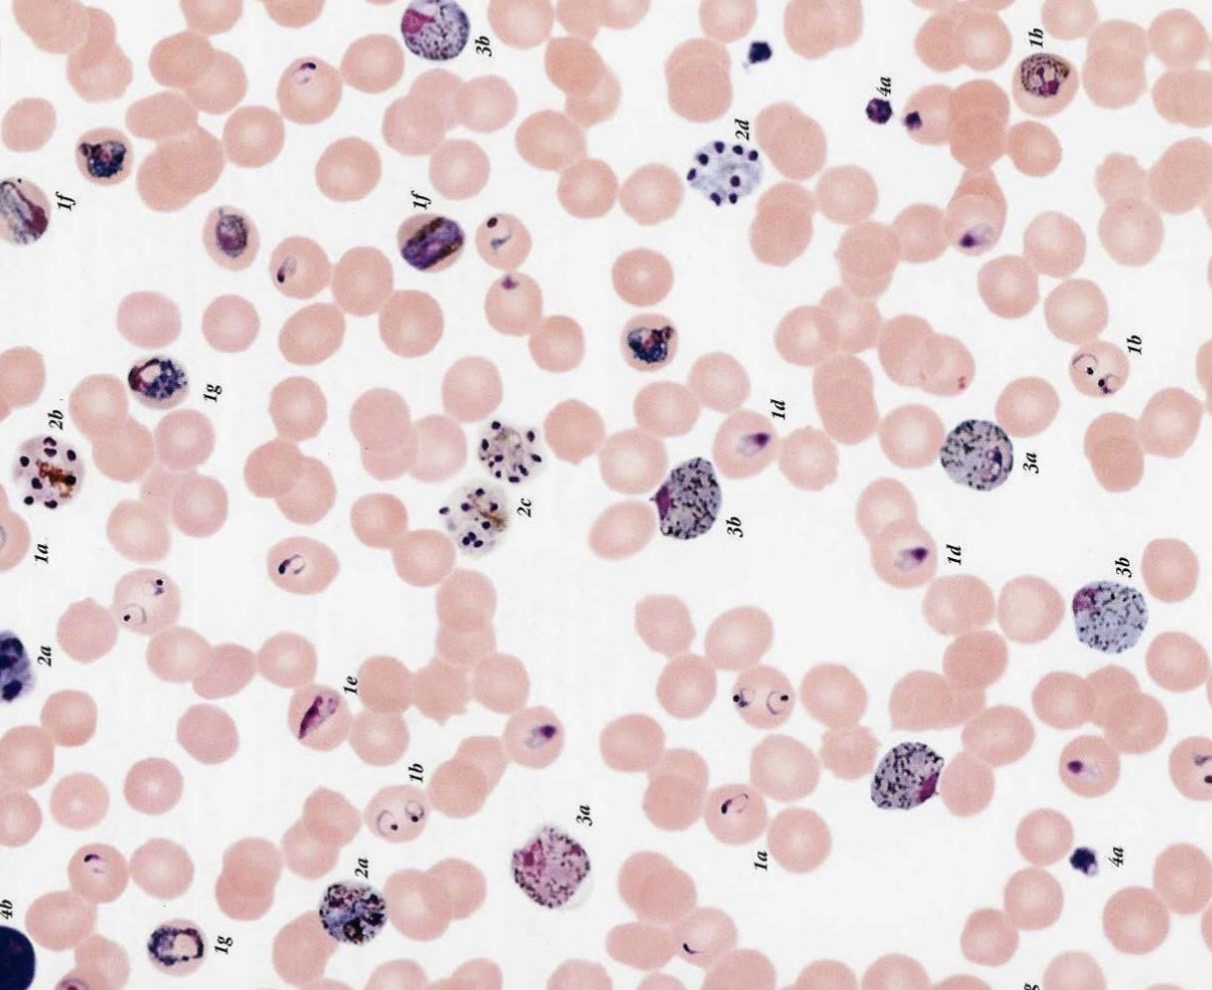
knowt flashcard image

1/31
Looks like no tags are added yet.
Name | Mastery | Learn | Test | Matching | Spaced | Call with Kai |
|---|
No analytics yet
Send a link to your students to track their progress
trofozoito de entamoeba histolytica/e.dispar

Quiste de Entamoeba histolytica / E.dispar

Quiste de entamoeba coli

Quiste de endolimax nana

Quiste de Iodameba butschlii

Trofozoito de entamoeba gingivalis

Forma vacuolar de blastocystis spp

Forma granular de blastocystis spp

Forma multivacuolar de blastocystis spp

Trofozoito de Giardia lamblia

Quiste de Giardia lamblia

Quiste de Chilomastix mesnili

Trofozoito de Chilomastix mesnili

Trichonomas vaginalis

Trichonomas hominis

Trichonomas tenax

Tripomastigote de Trypanosoma cruzi

Epimastigote de Trypanosoma cruzi

Tripomastigote de Trypanosoma brucei

Tripomastigote de Trypanosoma rangeli

mosca glossina o tse tse

Amastigote de Leishmania spp

Promastigote de Leishmania spp

lutzomyia / phlebotomus

Trofozoito Balantidium coli

Quiste de Balantidium coli

Anopheles

Plasmodium falciparum
Plasmodium vivax
Plasmodium malarie
Ooquiste de toxoplasma gondii

Taquizoito de Toxoplasma gondii
